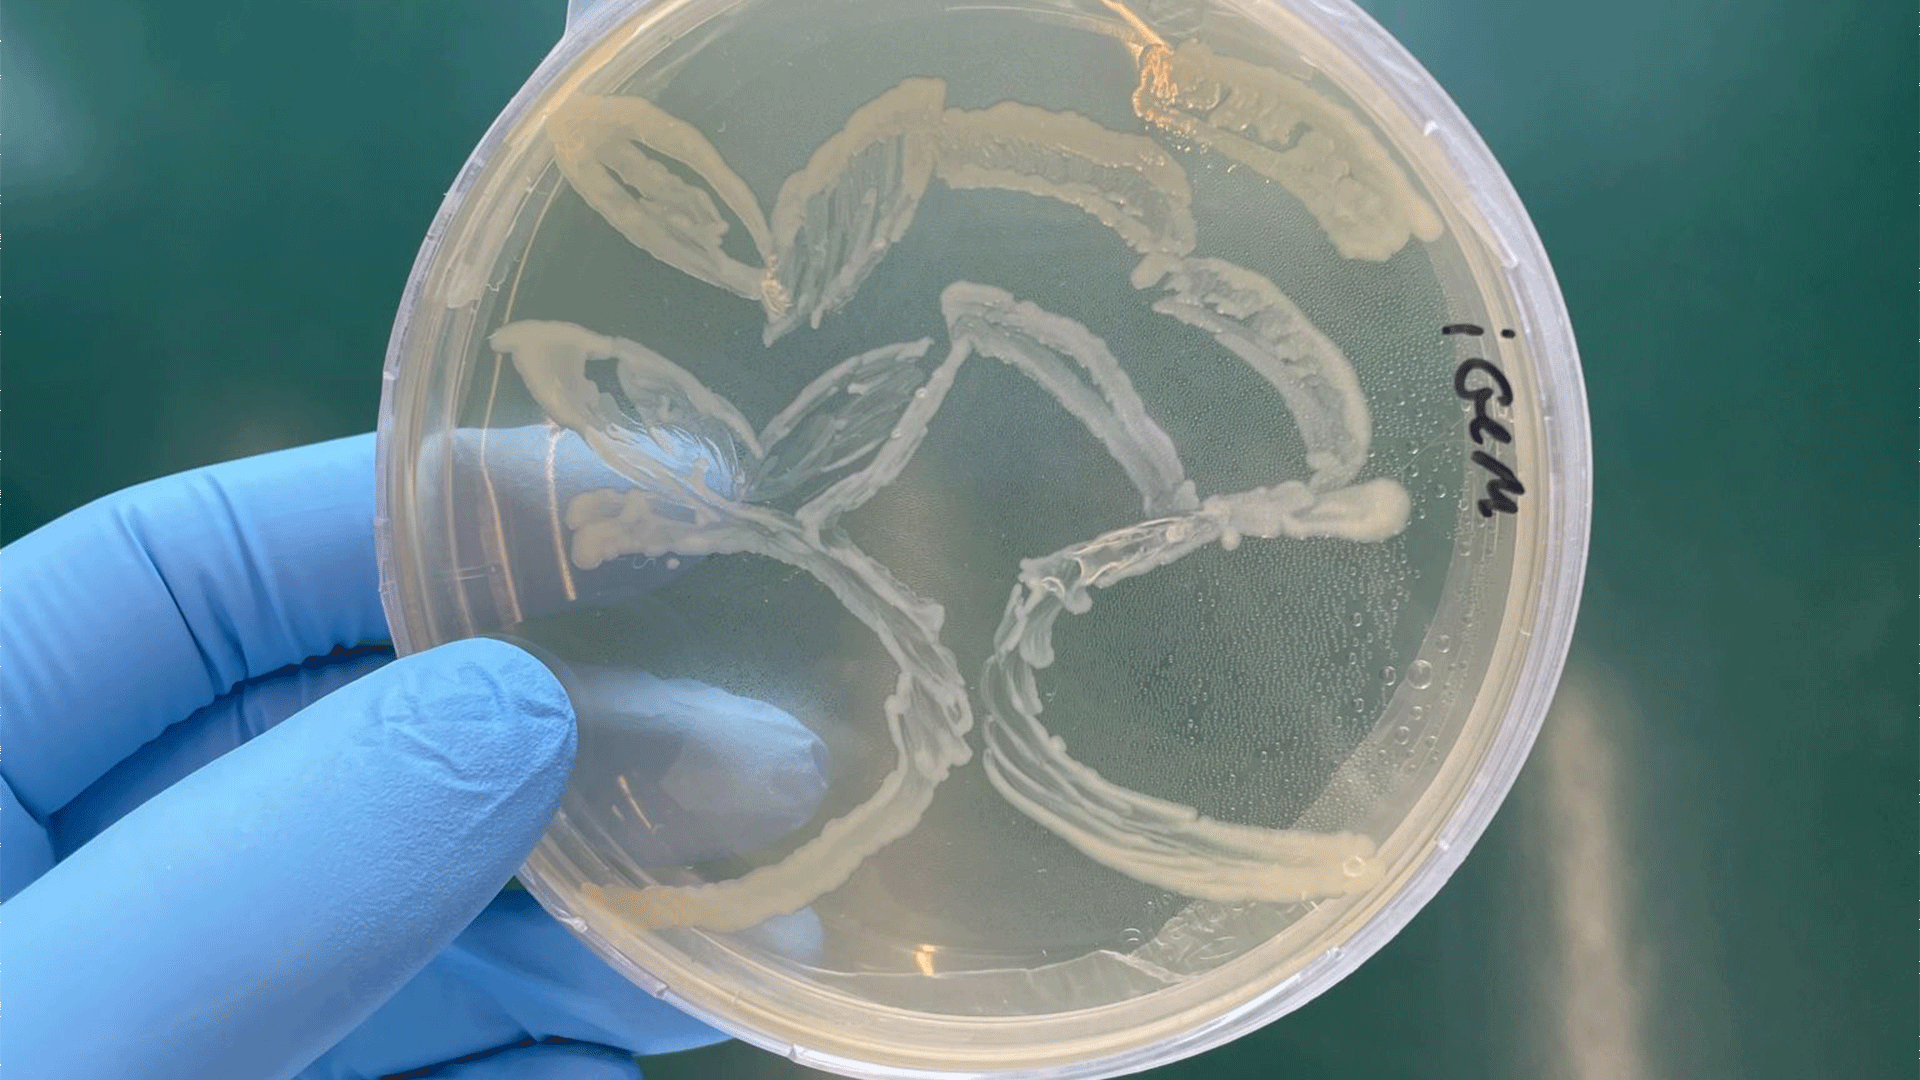

Interdisziplinäres Studierendenprojekt SwissCas der FHNW gewinnt Silbermedallie bei iGEM-Wettbewerb
Das Projekt SwissCas von Master-Studierenden der Hochschule für Life Sciences FHNW und Angelica Bebing, Studierende im Master-Studiengang Digital Communication Environments der HGK Basel, gewann am iGEM-Wettbewerb eine Silbermedaille.
Die International Genetically Engineered Machine (iGEM) ist eine internationale Organisation, die sich der Förderung der synthetischen Biologie und dem Aufbau einer globalen Synbio-Community durch Bildung und Wettbewerbe verschrieben hat. Gleichzeitig pflegt sie eine offene, kollaborative und kooperative Gemeinschaft, die sich für Lösungen für eine gesündere, widerstandsfähigere und nachhaltigere Welt einsetzt.
Der jährlich weltweit ausgeschriebene Wettbewerb der iGEM bietet multidisziplinär zusammengesetzten Studierendenprojekten einen Anreiz, Projekte zu entwerfen, zu entwickeln, zu testen und zu präsentieren, die sich mit den drängendsten Problemen unserer Zeit auseinandersetzen.
Das aus Studierenden verschiedener Master-Studiengänge der Hochschule für Life Sciences FHNW und Angelica Bebing, Studierende im Master-Studiengang Digital Communication Environments der HGK Basel, bestehende Projekt SwissCas hat ein Testverfahren entwickelt, welches die Bekämpfung einer neuartigen Kartoffelerkrankung stark vereinfacht. Das Projekt wurde dafür bei der iGEM 2025 Competition mit einer Silbermedallie ausgezeichnet.
Das FHNW-Studierendenprojekt SwissCas verfolgt das Ziel, ein schnelles, benutzerfreundliches Testgerät auf Basis der CRISPR-Cas12a-Technologie zu entwickeln. Mit diesem Tool soll Landwirt:innen eine zugängliche Alternative zu den derzeitigen qPCR-basierten Diagnosemethoden geboten werden, die spezielle Geräte und Labore erfordern. Anstatt sich auf zentralisierte Tests zu verlassen, könnten Landwirt:innen ihre eigenen Pflanzen direkt auf dem Feld untersuchen und schnelle Ergebnisse erhalten.
Dies ist besonders wichtig, da es noch keine Behandlung für bereits mit dem Bakterium Arsenophonus phytopathogenicus infizierte Pflanzen gibt. Die einzigen verfügbaren Strategien sind präventiver Natur: Anpassung der Fruchtfolge, um Wirtspflanzen zu vermeiden, die das Bakterium beherbergen, oder Versuch, den Insektenvektor (Pentastiridius leporinus) mit Insektiziden zu bekämpfen. Beide Ansätze bieten nur einen teilweisen Schutz und erfordern zeitnahe Informationen darüber, ob und wo der Erreger vorhanden ist.
Indem SwissCas Landwirt:innen die Möglichkeit bietet, ihre Felder in Echtzeit zu überwachen, kann der von SwissCas entwickelte Test die epidemiologischen Erkenntnisse liefern, die für fundierte Entscheidungen erforderlich sind. Mit einer genauen Erkennung vor Ort können Landwirt:innen die Fruchtfolge besser planen, eine gezielte Schädlingsbekämpfung durchführen und letztendlich das Risiko einer unbemerkten Ausbreitung des Erregers verringern.
Angelica Bebing, Studentin im Master-Studiengang Digital Communication Environments des Institut Digital Communication Environments (IDCE) der HGK Basel ist als Mitglied des SwissCas-Teams für die Entwickung diverser Kommunikationsmittel zuständig. Die Vermittlung der wissenschaftlichen Erkenntnisse über unterschiedliche Medien ist ein zentrales Anliegen des SwissCas-Teams.
Wir gratulieren dem ganzen FHNW-Studierendenprojekt SwissCas und besonders auch Angelica Bebing zu dieser bedeutenden Auszeichnung!